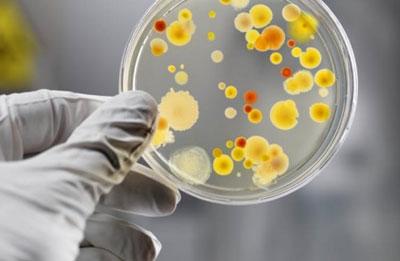
Посев на тиф

Системная болезнь брюшной тиф – это заболевание, относящееся к группе острых кишечных инфекций. Оно сопровождается серьезной интоксикацией, лихорадкой и появлением сыпи. Каждый год в мире фиксируется до 20 млн случаев заболевания людей тифом. Отсутствие своевременного лечения в совокупности с низким иммунитетом в 12% случаев приводит к летальному исходу пациентов.
Характеристика возбудителя заболевания
Возбудителем брюшного тифа является грамположительная палочка, характеризующаяся высокой устойчивостью к внешним условиям. На почве и в водной среде она сохраняет жизнеспособность до 5 месяцев, в фекальных выделениях – до 3 недель, в продуктах питания – 2-3 недели. Замораживание не причиняет бактерии Salmonella typhi никакого вреда, а кипячение либо воздействие дезинфектантов вызывает ее гибель.
Проникая в организм человека, этот микроорганизм начинает выделять токсины, оказывающие общее отравляющее действие и вызывающие патологии в функционировании некоторых органов и систем.
Заболевание, вызванное сальмонеллой, характеризуется абсолютной восприимчивостью человеческого организма к возбудителю. После его излечения у человека вырабатывается устойчивый иммунитет.
В последние годы все чаще встречаются случаи повторного заражения человека брюшным тифом. Врачи считают причиной этого явления длительное влияние на организм антибиотиков, обладающих иммунодепрессивным воздействием. Как результат – длительность и сила приобретенного иммунитета становятся все ниже.
Врачи отмечают, что брюшной тиф представляет собой серьезное инфекционное заболевание, вызываемое бактерией Salmonella typhi. Особенностью его развития является длительный инкубационный период, который может варьироваться от нескольких дней до нескольких недель. Симптомы, как правило, начинаются с высокой температуры, головной боли и общего недомогания, что затрудняет раннюю диагностику. Врачи подчеркивают, что без своевременного лечения болезнь может привести к серьезным осложнениям, таким как перфорация кишечника.
Протекание заболевания может быть различным: у некоторых пациентов наблюдается легкая форма, в то время как другие сталкиваются с тяжелыми проявлениями. Важно отметить, что у детей и пожилых людей риск осложнений значительно выше. Врачи рекомендуют вакцинацию и соблюдение санитарных норм как основные меры профилактики. Своевременное обращение за медицинской помощью и адекватное лечение антибиотиками играют ключевую роль в успешном выздоровлении.
https://youtube.com/watch?v=A5abRbQm_rg
Причины и пути заражения тифом
Носителем брюшного тифа является зараженный человек. На заключительной стадии инкубационного периода происходит выделение палочки-возбудителя во внешнюю среду. Этот процесс длится в течение развития заболевания в период проявления клинических симптомов. При остром носительстве инфекции он может продолжаться некоторое время после излечения, а при хроническом – всю жизнь.
Заболевание характеризуется фекально-оральным путем передачи, который осуществляется тремя способами:
- Водный метод передачи реализуется путем употребления зараженной сальмонеллой воды из открытых водоемов или водопроводных сетей. Одной из причин такого явления могут стать аварийные ситуации на сетях водопровода, по причине которых в питьевую воду проникают канализационные стоки или инфицированные грунтовые воды. В результате таких обстоятельств могут наблюдаться очаговые вспышки заболевания острого или хронического характера, которые способны охватить большое количество населения.
- Пищевой способ передачи брюшнотифозного возбудителя заключается в приеме инфицированных продуктов питания. Такой вариант возможен при употреблении фруктов или овощей, для полива которых используются сточные или обогащенные удобрениями воды. Тифозные бактерии могут присутствовать и размножаться в таких продуктах, как молоко, творог, сметана, мясной фарш, холодец.
- Контактно-бытовой путь распространения заболевания предполагает заражение окружающих предметов инфицированным человеком в результате недостаточно качественной гигиены. Впоследствии происходит заражение пищи и проникновение возбудителя в пищевую систему организма.
Стадии развития заболевания
После проникновения сальмонеллы в человеческий организм происходит такая последовательность ее распространения и воздействия:
- Поступление определенного количества возбудителя инфекции, требуемого для развития заболевания, в терминальный отдел подвздошной кишки.
- Возникновение хронического воспаления в результате проникновения бактерии в слизистую оболочку тонкой кишки.
- Внедрение бактерий в лимфоидную ткань с поражением пейеровых бляшек и регионарных лимфоузлов.
- Поступление инфекции в кровеносную систему и распространение по всему организму. В печени и селезенке происходит размножение бактерии, результатом которого становится поражение этих органов.
- Запуск иммунных реакций организма в ответ на циркуляцию бактерий-возбудителей в системном кровотоке. В это время начинается разрушение патогенных микроорганизмов силами иммунной системы, в результате чего происходит выделение токсинов и общая интоксикация организма.
Описанные стадии развития заболевания могут повторяться. Полное разрушение и обезвреживание бактерии, вызывающей тиф, происходит после достаточного усиления иммунной системы.
Брюшной тиф — это инфекционное заболевание, вызываемое бактерией Salmonella typhi, и его развитие вызывает множество обсуждений среди медиков и пациентов. Люди отмечают, что симптомы могут проявляться постепенно, начиная с высокой температуры, головной боли и слабости, что затрудняет раннюю диагностику. Важно понимать, что заболевание передается через загрязненные воду и пищу, что делает профилактику особенно актуальной в регионах с низким уровнем санитарии. Многие пациенты делятся опытом о том, как важна своевременная медицинская помощь и правильное лечение, включая антибиотики. Также обсуждаются последствия, такие как возможные осложнения, которые могут возникнуть при отсутствии лечения. В целом, осведомленность о симптомах и путях передачи брюшного тифа играет ключевую роль в его предотвращении и контроле.
https://youtube.com/watch?v=tzOAxWEXIT4
Симптомы
Брюшной тиф в большинстве случаев имеет ярко выраженную симптоматику, которая зависит от стадии развития заболевания.
Инкубационный период
От проникновения возбудителя брюшного тифа до появления первых признаков заболевания чаще всего проходит от 10 до 15 дней. Однако в некоторых случаях инкубационный период может затянуться до 3-5 недель. Это зависит от количества попавшего в организм возбудителя и способа его проникновения. Так, заражение через пищу характеризуется малым скрытым периодом – около 7-8 дней. При проникновении инфекции с водой период инкубации достигает 2 недель. В случае острого начала заболевания скрытый период не превышает 1-2 дней, по истечении которых проявляются ярко выраженные клинические симптомы.
На этом этапе происходит продвижение возбудителя в тонкую кишку сквозь пищеварительный тракт и проникновение в лимфоидную систему. Бактерии активно множатся и спустя некоторое время поступают в системный кровоток. В этот момент скрытый период завершается и у человека возникает первичная симптоматика.
Во время инкубационного периода у зараженного человека отсутствуют специфические симптомы заболевания, однако может наблюдаться слабость, высокая утомляемость.
https://youtube.com/watch?v=BYf8xNUsXCo
Начальная стадия
Стадия развития заболевания предполагает распространение возбудителя брюшного тифа по кровотоку и активизацию иммунной системы для борьбы с ним. В результате этого процесса происходит выделение из патогенных микроорганизмов эндотоксинов, которое приводит к интоксикации организма. Длительность этой стадии составляет около 7 дней.
Симптоматика начала заболевания выражена достаточно слабо. У человека может незначительно повышаться температура тела с достижением максимальной отметки к 5-6 дню.
Постепенно у человека проявляются следующие симптомы брюшного тифа:
- Медленное повышение температуры тела, достигающее максимальной отметки в 39-40 градусов к 5-6 дню.
- Общее отравление организма проявляется в головных и мышечно-суставных болях, слабости, ухудшении сна и аппетита, головокружениях. Артериальное давление чаще всего снижается, а дыхание учащается, присутствует тахикардия.
- О поражении пищеварительной системы свидетельствуют интенсивные схваткообразные боли в правой стороне живота, нарушение пищеварения, отражающееся в сменяющих друг друга диарее и запорах. В некоторых случаях возникают кишечные кровотечения. Отсутствие лечения на данном этапе может привести к разрушению соединительнотканного каркаса кишечника, образованию на его стенках прободных язв и развитию перитонита. При внешнем осмотре специалист диагностирует увеличение толщины языка с отпечатками зубов, проступающими на его боковых поверхностях. Мышечный орган покрыт налетом серовато-белого цвета, зёв имеет покраснение, а миндалины заметно увеличены.
- Центральная нервная система сигнализирует об интоксикации такими симптомами: бледность кожных покровов, онемение и охлаждение конечностей, апатия. У многих больных наблюдается дезориентация в пространстве и времени. При остром развитии заболевания на этой стадии может возникнуть психическое расстройство – делирий, и как следствие – кома.
Стадия разгара заболевания
Период развернутого течения брюшного тифа продолжается на протяжении 5-7 дней, однако при тяжелом течении заболевания может достигать двух недель. В это время происходит поглощение возбудителя особыми клетками организма. При этом бактерии продолжают в них развиваться и размножаться. Такая ситуация ведет к нарушению функционирования иммунной системы человека.
На стадии разгара заболевания поражение органов желудочно-кишечного тракта выражается следующими симптомами:
- сухость и растресканность губ;
- образование на языке кровоточащих трещин;
- вздутие и сильная болезненность живота;
- признаки холецистита.
В этот период наблюдается увеличение размеров печени и селезенки, их болезненность, особенно при пальпации. Из-за нарушений в функционировании печени ладони приобретают желтый оттенок.
Реакцией почек на распространение сальмонеллы становится снижение количества выделяемой мочи. В дальнейшем у человека могут наблюдаться признаки пиелита и цистита.
Поражение захватывает и дыхательную систему организма. У человека прослушиваются рассеянные хрипы, дыхание становится жестким. В ряде случаев происходит развитие бронхита, который при отсутствии лечения переходит в пневмонию.
Стадия разгара заболевания характеризуется развитием брадикардии, раздвоением пульсовой волны, снижением давления. У пораженного человека может наблюдаться сердечно-сосудистая недостаточность.
Распространение возбудителя инфекции на кожные покровы вызывает возникновение на груди и животе сыпи – небольших бледно-розовых пятнышек размером около 3 мм. Они исчезают при нажатии и вскоре вновь проявляются. Средняя длительность присутствия таких высыпаний составляет 3-5 дней. После их исчезновения на кожных покровах некоторое время заметны неяркие пигментные пятна.
Реакцией центральной нервной системы на нарастание интоксикации организма становится сонливость и апатия, безынициативность больного. Человек впадает в состояние ступора, плохо ориентируется в пространстве, с трудом узнает окружающих людей.
Период ослабевания симптомов
Этап разрешения болезни зачастую длится не более недели. В это время у человека ослабевают все имеющиеся симптомы брюшного тифа. Температура тела снижается, однако не достигает нормальной отметки. Происходит нормализация сна и аппетита, уменьшается головная боль и увеличивается количество выделяемой мочи. Язык приобретает естественный вид: трещины заживляются, а налет исчезает.
Признаки улучшения состояния человека сопровождаются слабостью, эмоциональной неустойчивостью, снижением веса. В этот период могут обнаружиться запоздалые осложнения, вроде холецистита или тромбофлебита.
Период выздоровления
Выздоровление человека характеризуется нормализацией температуры тела, восстановлением всех нарушенных функций и устранением из организма возбудителя заболевания. Однако в 2-5% случаев переболевший человек становится хроническим носителем бактерии Salmonella typhi. Нарушения в функционировании вегетативной системы зачастую наблюдаются на протяжении 3-4 недель после выздоровления.
Рецидив
У 8-10% людей, зараженных брюшным тифом, могут случаться рецидивы заболевания. Зачастую они происходят во 2-3 неделю после нормализации температуры тела и могут повторять единоразово или многократно.
Предрецидивное состояние характеризуется субфебрильной температурой, сохранением увеличенного размера селезенки и печени, замедлением темпа освобождения языка от налета. Постепенно к человеку возвращаются клинические симптомы стадии разгара заболевания с более быстрым увеличением температуры тела и менее острым протеканием.
Формы заболевания
Не всегда симптомы брюшного тифа могут выражаться в описанной форме и последовательности.
Некоторые формы заболевания могут включать неспецифические признаки наличия инфекции
:
- Абортивная форма брюшного тифа характеризуется классическим стартом заболевания, которому присущи повышение температуры, общая слабость, нарушения в функционировании органов ЖКТ. К 5-6 дню после возникновения симптомов заболевания они резко исчезают, и происходит нормализация состояния человека.
- Атипичные и стертые формы тифа характеризуются слабовыраженной симптоматикой. Температура тела редко превышает предел в 38 градусов, болезненность в области живота незначительна, а кожные высыпания могут отсутствовать.
Осложнения
Интоксикация организма, вызванная развитием и гибелью в нем бактерий, вызывает нарушение функционирования большинства органов и систем. Осложнения брюшного тифа могут быть специфическими и неспецифическими. Их тяжесть зависит от сложности протекания заболевания, возраста пациента, состояния его иммунитета и наличия сопутствующих заболеваний.
Неспецифические
Общие или неспецифические осложнения брюшного тифа представляют собой патологии, которые могут быть следствием множества заболеваний:
- воспаление легких;
- миокардит;
- воспаление вен;
- пиелонефрит;
- цистит;
- простатит;
- менингит;
- воспаление суставов.
Специфические
Специфические осложнения представляют собой последствия заболевания, которые присущи только брюшному тифу. Специалисты выделяют три ключевых патологии, которые могут оказать серьезное воздействие на здоровье человека:
- Кишечное кровотечение способно возникнуть в середине 2-3 недели протекания заболевания. В некоторых случаях это осложнение активизируется на этапе выздоровления. Кал содержит примеси крови, сгустки и становится дегтеобразным. При незначительном кровотечении, его своевременной диагностике и лечении прогноз благоприятный. Обширное кровотечение может привести к возникновению геморрагического шока.
- Перфоративный перитонит – очень опасное специфическое осложнение при брюшном тифе, которое может возникнуть как при тяжелом, так и при легком протекании заболевания. К перфорации может привести повышенная перистальтика кишечника, сильный метеоризм. Опасность патологии заключается в том, что ярко выраженные симптомы появляются достаточно поздно. Оперативное вмешательство должно быть произведено в течение 6 часов после перфорации кишечника. В иных случаях прогноз неблагоприятный.
- Инфекционно-токсический шок сопутствует стадии разгара тифа. Он начинается с повышения температуры тела и ведет к постепенному нарушению функционирования всех органов и систем и их разрушению, результатом чего может стать смертельный исход.
Течение брюшного тифа у детей
Брюшной тиф у детей до года встречается очень редко и характеризуется высокой тяжестью протекания.
Ключевыми признаками болезни являются ускорение пульса, тихие сердечные сокращения и высокая степень интоксикации
.
У детей до 5 лет начало заболевания является достаточно острым. Со стороны желудочно-кишечного тракта возникают симптомы, схожие с гастроэнтеритом: многократная рвота, диарея. Может возникнуть обезвоживание организма. Нередко возникают судорожные и бредовые состояния, повышенная слабость, снижение давления, нарушение сознания. Среди осложнений встречаются такие заболевания, как бронхит, отит, пневмония. Специфические последствия брюшного тифа в виде перфорации стенок кишечника и кровотечений обычно не наблюдаются.
У детей старше 5 лет развитие тифа происходит постепенно и не отличается от особенностей протекания у взрослых людей. Среди осложнений могут развиваться прободения и кишечные кровотечения.
Диагностика
Диагностика брюшного тифа представляет собой комплекс мероприятий, включающий сбор анамнеза, клинический осмотр пациента и методы обследования. На данном этапе важно дифференцировать заболевание от сальмонеллеза тифоподобной формы, паратифов, экзантемных инфекций.
В соответствии с клиническими рекомендациями лабораторное подтверждение брюшного тифа осуществляется при помощи общеклинических, бактериологических и серологических анализов:
- Общеклинические анализы при брюшном тифе заключаются в исследовании крови и мочи, они позволяют выявить наличие воспалительного процесса и общее состояние организма.
- Бактериологические анализы направлены на выявление возбудителя заболевания с помощью посева крови, мочи, кала и желчи.
- Серологические анализы предназначены для выявления в крови зараженного человека антител и особых антигенов.
В случае наличия подозрения на поражение определенных органов и систем при брюшном тифе применяют инструментальную диагностику. В зависимости от имеющихся симптомов пациенту могут быть назначены следующие исследования:
- УЗИ органов брюшной полости, почек, лимфоузлов;
- рентген грудной клетки;
- ультразвуковое обследование сердца;
- гастродуоденоскопия;
- электрокардиограмма;
- электроэнцефалография.
Лечение
Пациенты с подозрением на брюшной тиф подлежат обязательной госпитализации в инфекционное отделение лечебного учреждения. На стадии разгара заболевания обязательным требованием является строгий постельный режим – пациенту разрешено сидеть начиная с 8-го дня понижения температуры, ходить – после 10 дней.
Лечение брюшного тифа включает в себя совокупность следующих мероприятий:
- Антибиотикотерапия. В условиях медицинского стационара используются препараты с направленностью против бактерии Salmonella typhi. К их числу относят левомицетин, ампициллин, ципрофлоксацин, амоксициллин, цефалоспорины 3-го и 4-го поколения.
- Дезинтоксикационная терапия. Пациентам вводятся коллоидные и кристаллоидные растворы для устранения признаков интоксикации: раствор рингера, 5%-й раствор глюкозы. При тяжелом протекании заболевания используют кортикостероидные препараты и оксигенотерапию.
- Симптоматическая терапия. Пациенту назначаются лекарства, направленные на стабилизацию гемодинамики, купирование почечной недостаточности, улучшение циркуляции крови.
- Общеукрепляющая терапия. Помимо специфического лечения, больному назначаются витаминные комплексы, иммуномодуляторы, сорбенты, пробиотики.
- Диетотерапия. В период лечения брюшного тифа необходимо придерживаться лечебного питания, которое способствует более щадящему воздействию на кишечник. Питание должно быть дробным и частым, не содержать продуктов, вызывающих процессы брожения.
Выписка пациентов, поступивших с диагнозом «брюшной тиф», осуществляется по результатам бактериологических проб, которые должны быть отрицательными. Зачастую это происходит не ранее 3 недель с момента понижения температуры тела до показателя нормы.
Большинство случаев заболевания брюшным тифом завершаются полным излечением зараженного человека и восстановлением всех функций его организма. Отрицательный прогноз может встречаться в случаях запоздалого обращения в медицинское учреждение, повлекшего за собой развитие таких осложнений, как обширное кишечное кровотечение или прободение стенки кишечника.
Профилактика
Меры по предупреждению заражения брюшным тифом включают в себя действия по обеззараживанию источника инфекции, недопущение его передачи окружающим и повышение иммунитета.
Ключевым мероприятием специфической профилактики брюшного тифа является вакцинация. Существует несколько показаний к ее проведению:
- посещение стран и районов с высоким уровнем заболеваемости тифом;
- контакт с возбудителем инфекции вследствие работы с ним;
- регулярное взаимодействие с зараженными тифом людьми.
Существует два вида вакцин, используемых для профилактики заболевания у детей и взрослых:
- таблетки с высоким содержанием живых, но сильно ослабленных бактерий Salmonella typhi;
- инъекции препарата, содержащие неактивный возбудитель.
Общая профилактика брюшного тифа включает следующие мероприятия:
- соблюдение личной гигиены, тщательная обработка продуктов питания, контроль качества употребляемой воды;
- обязательное соблюдение санитарно-эпидемиологических правил при работе в заведениях общественного питания;
- проведение регулярного бактериологического исследования в случае перенесения заболевания для исключения его рецидива.
Сложность протекания брюшного тифа требует тщательного соблюдения мероприятий по недопущению заражения его возбудителем. При малейшем подозрении на инфицирование необходимо незамедлительно обратиться в лечебное учреждение.
Вопрос-ответ
Как развивается брюшной тиф?
Симптомы брюшного тифа обычно развиваются через 1-2 недели после заражения человека бактериями Salmonella typhi. При типичном течении заболевания выделяют начальный период, который длится около недели и характеризуется ежедневно нарастающей лихорадкой (температура тела до 40–40, 5оС) и симптомами интоксикации.
Каковы стадии патогенеза брюшного тифа?
Начальный, который продолжается 4-7 дней, пик болезни, продолжающийся 2-3 недели, стадия угасания симптомов.
Какие источники характерны для брюшного тифа?
Источником инфекции при брюшном тифе и паратифах является человек (больной или бактерионоситель). Клинически заболевание характеризуется лихорадкой, интоксикацией, поражением тонкого кишечника, сыпью на кожных покровах туловища. Возможно возникновение осложнений вследствие возникновения кишечного кровотечения.
Какое поражение характерно для брюшного тифа?
Брюшной тиф — это инфекционное заболевание с циклическим течением. Оно сопровождается воспалением кишечника (поражением местной лимфатической системы, внутренней выстилки сосудов), а также печени, органов брюшной полости. В некоторых случаях в расстройство вовлекается и легочная система.
Советы
СОВЕТ №1
Изучите симптомы брюшного тифа, такие как высокая температура, головная боль, слабость и расстройства пищеварения. Это поможет вам своевременно распознать заболевание и обратиться к врачу.
СОВЕТ №2
Обратите внимание на гигиену и санитарные условия. Регулярно мойте руки, особенно перед едой и после посещения туалета, чтобы снизить риск заражения.
СОВЕТ №3
Убедитесь, что вы и ваши близкие получили необходимые прививки. Вакцинация может значительно снизить вероятность заболевания, особенно если вы планируете поездки в регионы с высоким риском.
СОВЕТ №4
Следите за качеством пищи и воды, которую употребляете. Избегайте уличной еды и неочищенной воды, особенно в странах с низким уровнем санитарии, чтобы предотвратить заражение.